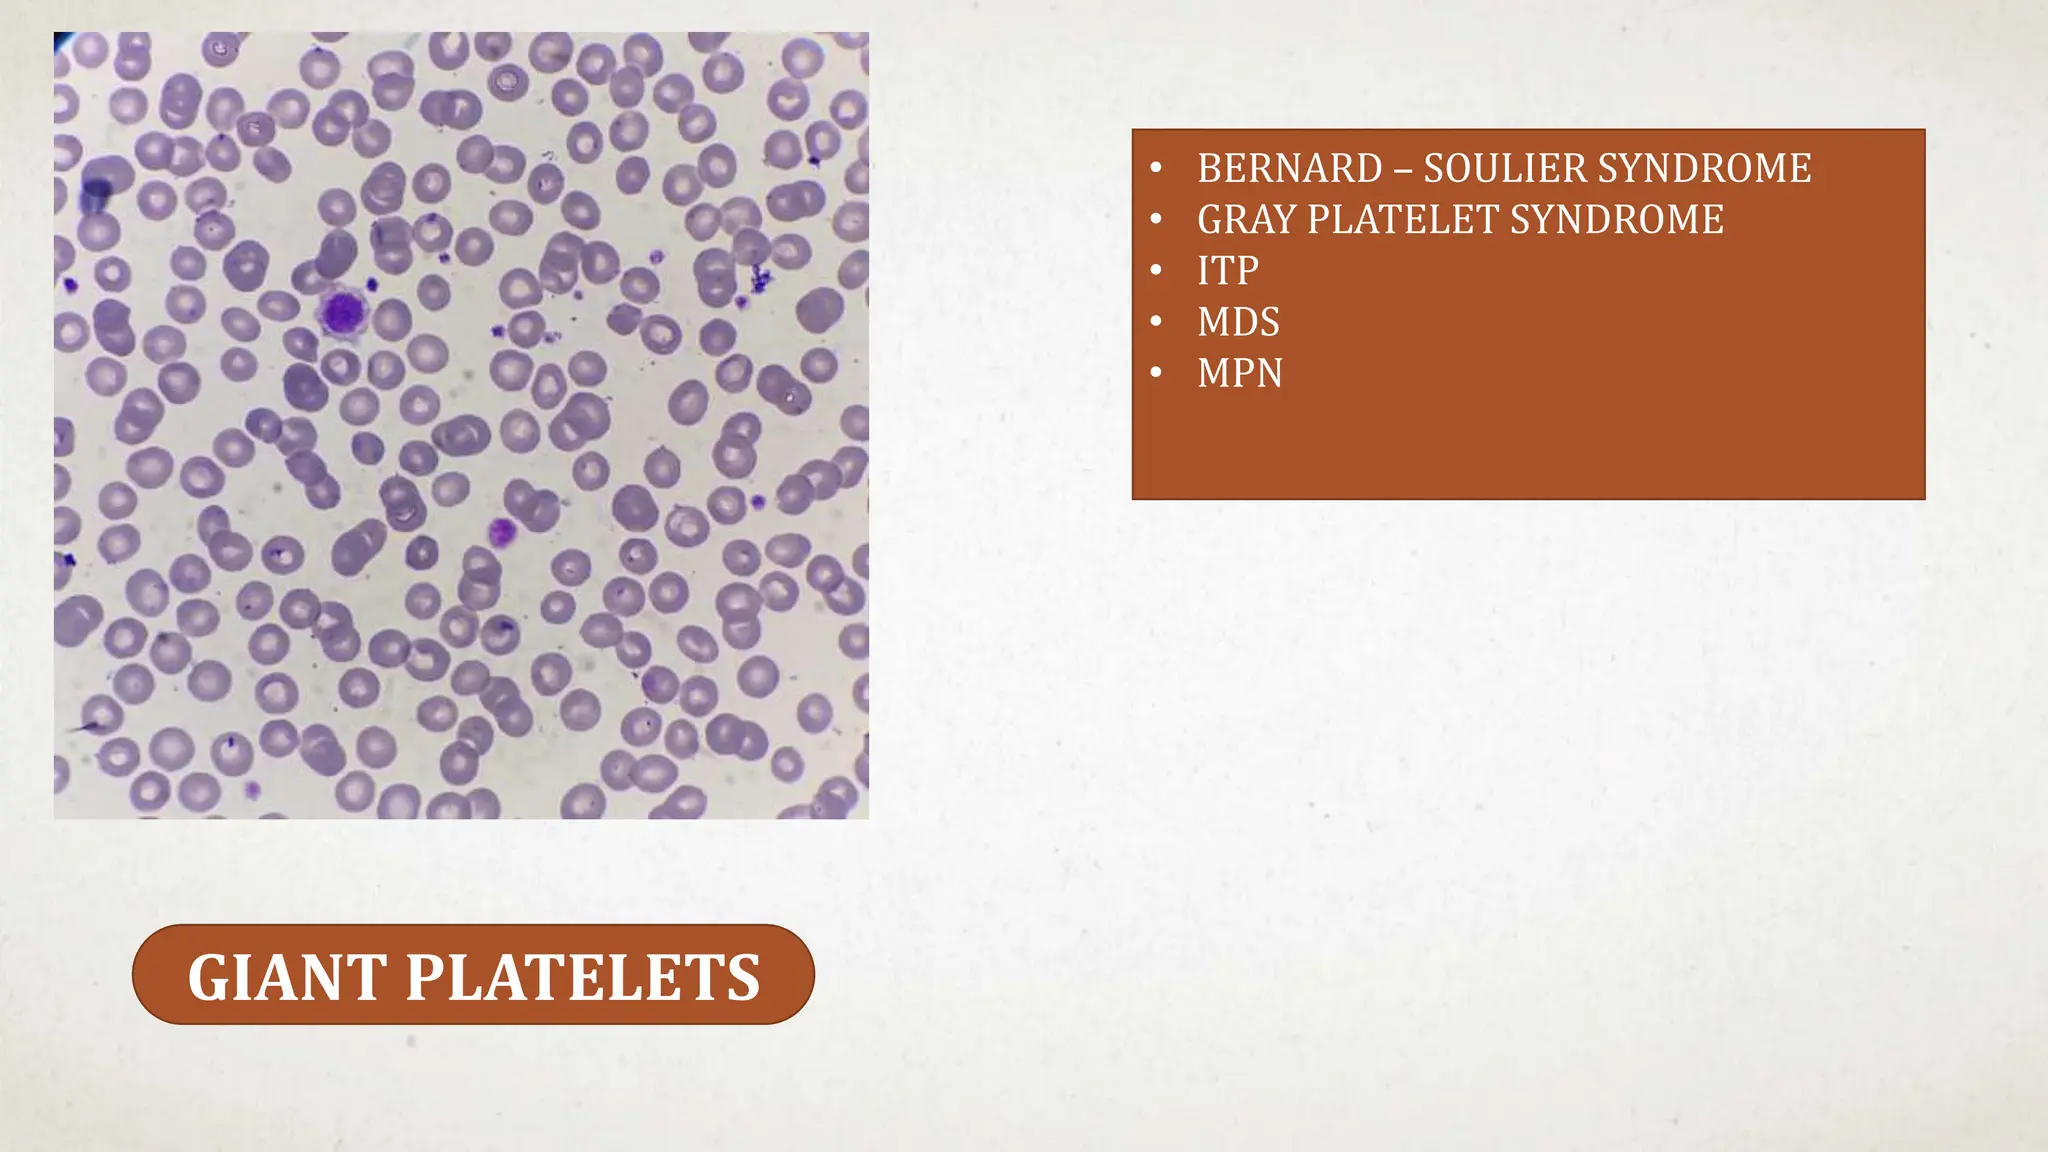
GIANT PLATELETS
• BERNARD – SOULIER SYNDROME
• GRAY PLATELET SYNDROME
• ITP
• MDS
• MPN

This case suggests a diagnosis of thrombocytopenia. The key features are:
- Recent history of infection suggesting a secondary cause
- Purpura and petechiae on examination
- No family history suggesting an acquired rather than inherited cause
- Thrombocytopenia is a likely diagnosis which would explain the bleeding manifestations.
Further workup should include a CBC with platelet count to confirm thrombocytopenia and evaluate for possible secondary causes like ITP.